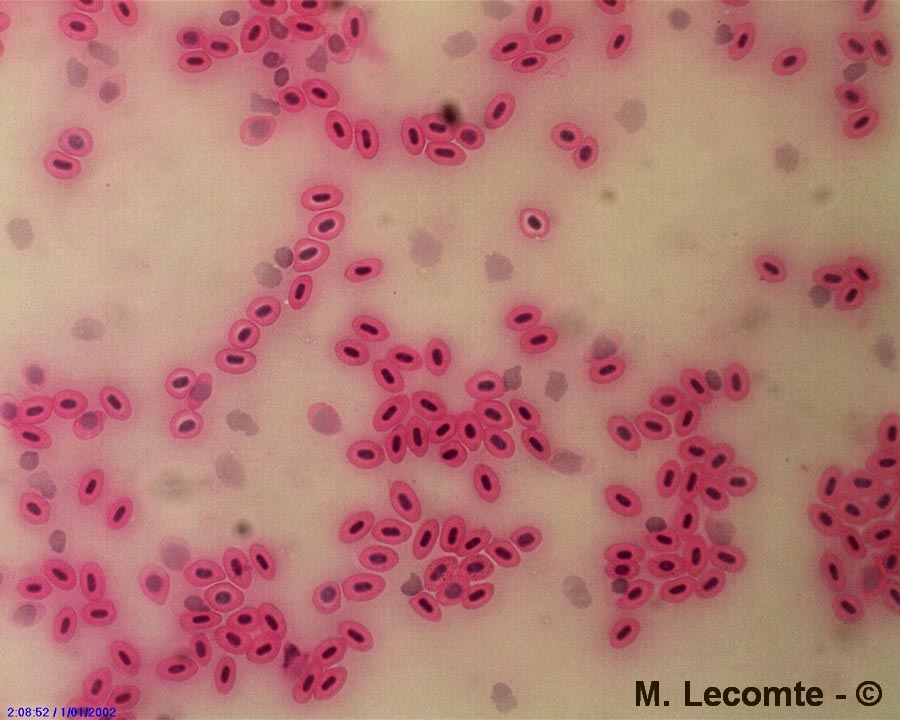

Société Wallonne de Microscopie (SWM).
Images - biologie générale.
Sang de poisson
(M. Lecomte)
Association des Mycologues Francophones de Belgique asbl |
| Retour |
Société Wallonne de Microscopie (SWM). Images - biologie générale. Sang de poisson
|